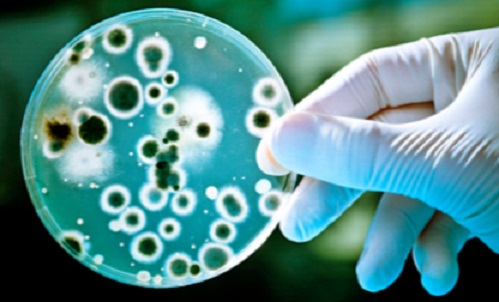

Les êtres vivants sur la terre vivent en parfait équilibre entre eux lorsque chacun d’eux respecte son environnement. Autrefois, le classement de ces êtres vivants, par plusieurs savants de leurs époques, notamment, Carl von Linné (1707-1778), Buffon (1707/1788), Georges Cuvier (1769–1832) ,entre autres, était basé sur les critères de ressemblance et de reproduction. Sur la base de ces critères, l’homme se distingue des végétaux, des animaux et des êtres microscopiques. Ces derniers, désignés sous le terme de « micro-organismes », sont invisibles à l’œil nu et pour les voir et les étudier en détail, il a fallu attendre la fabrication des microscopes. Ces outils, dont leur ancêtre était conçu dès 1665 par Antoni Van Leeuwenhoek (1632-1723), ont permis l’agrandissement des êtres minuscules plusieurs milliers de fois et, par conséquent, de déterminer leurs formes, leurs groupements et leurs ultra structures. Depuis ce temps, le monde microbien est né et les micro-organismes ont été classés en familles ; les familles en genres ; les genres en espèces, les espèces en souches et les souches en plusieurs biotypes et sérotypes. A titre d’exemple, Escherichia coli entérohémoragique O157:H7 est un sérotype de l’espèce bactérienne Escherichia coli qui appartient au genre Escherichia et à la famille des enterobacteriaceae.
Les premières formes microbiennes ont été alors observées par Antoni Van Leeuwenhoek en 1665 dans le tartre de ses dents, dans les matières fécales de l’homme et des animaux et dans le moût de bière. Il a pu convaincre la communauté scientifique de son époque de l’existence de ces particules vivantes invisibles à l’œil nu, mais actives dans leurs milieux. Des bactéries et des levures ont été alors observées et schématisées. Actuellement avec le rayonnement de la science microbiologique et de la technologie, l’homme est convaincu de l’existence de ce monde microbien aussi diversifié que complexe et qui cohabite avec lui sur la terre. De plus, non seulement il vit dans son environnement (eau, sol, air, débris végétaux,…), mais il tapisse également plusieurs parties de son corps (peau, muqueuses, intestins,…) et il est présent sur et dans tous les êtres vivants (végétaux, homme, animaux) sans exception.
Dans ce papier, on va s’intéresser plus particulièrement aux micro-organismes qui colonisent le tube digestif de l’homme et qu’on appelle plus communément « la flore microbienne intestinale ou microbiote intestinal». Le terme micro-organismes étant donné à tous les organismes cellulaires microscopiques (bactéries, levures, champignons microscopiques, protozoaires) à l’exception des virus qui sont considérés comme des particules non cellulaires mais actives, c'est-à-dire qu’ils peuvent infecter les cellules vivantes animales, végétales ou microbiennes et se multiplier dans ces cellules.
Groupes microbiens présents dans les intestins de l’homme en bonne santé : Flore microbienne intestinale
Parmi les premiers médecins qui ont travaillé sur la flore microbienne du tube digestif et sa relation avec la physiologie de la digestion, il y a un jeune pédiatre allemand, Theodore Escherich (1857-1911). Il a publié en 1886 une monographie sur les bactéries intestinales des nourrissons. Depuis ce temps, les études sur la flore intestinale de l’homme se sont multipliées pour déterminer les groupes microbiens qui la composent et leurs interactions avec le tube digestif. Elles ont montré que la flore intestinale de l’homme est constituée de plusieurs groupes de micro-organismes. En nombre, cette flore représente dix à cent fois plus de cellules que n’en contient le corps humain et peut atteindre 1014 unités ou cellules par gramme de matières fécales Elle se concentre, majoritairement, dans le gros intestin (côlon) où elle assure plusieurs interactions fonctionnelles et physiologiques.
La mise en culture du contenu intestinal (matières fécales) au début par des techniques bactériologiques classiques ou en anaérobiose (en absence d’oxygène), et plus tard par des techniques de biologies moléculaires développées, a permis de mettre en évidence plusieurs groupes de micro-organismes. Ces cultures ont mis en évidence une dominance bactérienne par rapport aux autres micro-organismes, ce qui a permis de les classer comme suit :
* Les micro-organismes anaérobies : ce groupe a pu être révélé grâce à l’évolution des techniques de culture en anaérobiose, c'est-à-dire en absence d’oxygène. Il est représenté par plusieurs genres. Les plus abondants sont cultivables dans les conditions de laboratoire et regroupent environ 400 espèces différentes, mais seule une quarantaine d’espèces constitue la flore dominante d’un individu. Ces espèces appartiennent aux genres Bacteroides, Eubacterium, Peptostreptococcus, Ruminococcus, Bifidobacterium, Fusobacterium.
* Les micro-organismes anaérobies facultatifs, c'est-à-dire ils peuvent êtres cultivés en absence ou en présence d’oxygène, sont moins représentés et composent la flore sous dominante (106 à 108 unités par gramme de matières fécales). Exemple de la bactérie la plus étudiée Escherichia coli.
* Les micro-organismes aérobies, c'est-à-dire ils ne peuvent se multiplier qu’en présence de l’oxygène, sont peu nombreux (106 unités par gramme de matières fécales) et souvent ils ne font que transiter dans le tube digestif.
D’une manière plus simple, on peut dire que l’ensemble de ces micro-organismes constitue ce qu’on appelle « la flore microbienne intestinale » et que cette flore dont le nombre est très élevé dans le côlon caractérisé par une motricité réduite et moins abondante dans l’intestin grêle, caractérisé par une motricité importante, est composée d’une:
• flore résidente, permanente et abondante capable de se multiplier dans le tube digestif et qui caractérise même un individu (c'est-à-dire chaque individu a sa propre flore intestinale). Cette flore est capable de se concerter avec certains organes de l’homme pour moduler l’expression de certains gènes des cellules intestinales afin de créer un environnement favorable à son implantation,
• flore de transit qu’on ne retrouve pas à chaque fois dans le tube digestif. Cette flore bactérienne provient de l’alimentation et appartient à différents genres bactériens. Par exemple, les probiotiques qui peuvent survivre dans le tube digestif sans le coloniser définitivement ou des espèces qui appartiennent à la famille des Enterobacteriaceae (Escherichia coli par exemple). et aux genres Streptococcus, Lactobacillus,…
Interactions entre la flore intestinale et le tube digestif
Aujourd’hui, il est bien connu que les micro-organismes qui constituent la flore intestinale interagissent ,d’une part, entre eux et ,d’autre part, avec les cellules du tube digestif de l’homme par le biais des mécanismes immunitaires et par les métabolites produits par les réactions de fermentation qui se produisent dans le tube digestif. Ces différentes interactions sont bénéfiques et parfois néfastes pour l’homme.
La flore intestinale n’a pas la même composition chez le nouveau-né, le nourrisson, l’enfant ou l’adulte. Elle varie en fonction des différentes parties du tube digestif, de l’alimentation, de l’hygiène de vie, de l’environnement et des traitements antibiotiques. Les espèces qui composent cette flore présentent un tropisme cellulaire et tissulaire spécifique et parviennent à s’implanter par endroit du tube digestif. Il existe aussi des relations d’interaction entre les différentes bactéries qui composent cette flore. Ces interactions jouent un rôle important dans la sélection, la possibilité de colonisation et la persistance de certaines souches pour faire partie de la flore résidente. A titre d’exemple, l’espèce bactérienne Escherichia coli est représentée par plusieurs souches dont quelques-unes parviennent à coloniser définitivement le milieu colique d’une personne et entrent en relation symbiotique avec elle, alors que d’autres sont de transit et sont particulièrement soit des formes potentiellement pathogènes qui peuvent entraîner plusieurs types d’infections soit des formes environnementales qui n’arrivent pas à s’implanter sur les tissus du côlon et qui se retrouvent éjectées avec les matières fécales en dehors de l’organisme.
Fonction de la flore microbienne intestinale
La flore microbienne intestinale est essentiellement bactérienne. Elle assure de nombreuses foncions bénéfiques. Notamment, des fonctions métaboliques (sources d’énergie, de certaines vitamines,…), des fonctions trophiques (développement du système immunitaire) et des fonctions de barrière (elle s’oppose à l’implantation des germes pathogènes). L’implantation de chaque groupe de micro-organismes au niveau du tube digestif (œsophage, estomac, intestin grêle, gros intestin) est fonction de ses paramètres physiologiques. En effet, dans l’estomac à pH acide, ces cellules microbiennes sont soient détruites soit elles transitent. Certaines cellules par contre trouvent le moyen de coloniser les parois de cette cavité, comme c’est le cas de la bactérie Helicobacter pylori responsable de l’ulcère de l’estomac.
Au niveau de l’intestin grêle, le pH est neutre et le niveau d’oxygène est faible. Dans ces conditions, plusieurs espèces microbiennes parviennent à séjourner pour quelque temps pour transiter ensuite vers le côlon. Au niveau des différents segments du côlon (ascendant, transverse, descendant et sigmoïde), l’implantation des micro-organismes est importante et elle est favorisée grâce au transit ralenti, à l’absence d’oxygène et à la présence du mucus (le mucus est un gel translucide de 50 à 450 μM d’épaisseur, adhérent à la muqueuse et filant,il est formé de polymères de mucoglycoprotéines sécrétés par des cellules épithéliales) et à la nature des substances nutritives disponibles (les glucides et les protéines non digérés dans la partie supérieure du tube digestif, ainsi que par les sécrétions endogènes). Toutes ces conditions favorisent l’installation d’une flore résidente essentiellement anaérobie, riche et variée et dont la composition change d’un segment à l’autre. D’un autre côté, il se produit un échange entre les différentes composantes de la flore microbienne et les cellules tissulaires du côlon, ce qui contribue à l’amélioration du système immunitaire de l’homme.
Causes du déséquilibre de la flore intestinale
Quel que soit l’âge d’une personne en bonne santé, un équilibre se crée entre les différents groupes de micro-organismes qui constituent sa flore intestinale. Chaque groupe cohabite avec l’autre en parfaite harmonie et se localise dans une partie du tube digestif en fonction des particularités physiologiques de chaque compartiment et constitue une sorte de barrière qui s’oppose à l’implantation des germes de transit. En cas de problèmes de santé liés à une mauvaise alimentation (alimentations non équilibrées, alimentations contaminées par des microbes ou des substances toxiques,…), à une antibiothérapie mal contrôlée ou autre, il se produit un déséquilibre de la flore intestinale, ce qui entraîne plusieurs maladies intestinales aiguës ou chroniques telles que les diarrhées, le syndrome de l’intestin irritable (SII), la maladie de Crohn (MC), rectocolite hémorragique (RCH) et les cancers coliques. Cependant, la flore intestinale peut être améliorée :
* en régulant certains facteurs abiotiques comme le pH, le mucus, la vitesse de transit,
* en ajoutant dans l’alimentation de nouveaux micro-organismes vivants en quantités adéquates et présentant la particularité d’influencer de manière bénéfique la fonction des intestins de l’homme. Les bactéries lactiques, la levure de bière et d’autres probiotiques sont utiles dans ce cas. Les probiotiques, selon la définition de l’OMS, sont des micro-organismes vivants qui, lorsqu’ils sont administrés en quantités adéquates, produisent un bénéfice pour la santé de l’individu.
* en éliminant les germes en cause avec une antibiothérapie contrôlée,
* en améliorant l’apport des facteurs nutritionnels aux micro-organismes de la flore intestinale résidente par l’apport de fibres alimentaires ou de prébiotiques. Les prébiotiques sont des ingrédients alimentaires non digestibles, comme les acides biliaires par exemple, qui stimulent de manière sélective, au niveau du côlon, la multiplication ou l’activité de certains groupes bactériens susceptibles d’améliorer la fonction intestinale tels que les bactéries lactiques appartenant au genre Bifidobacterium.
Les conséquences de ce déséquilibre sur la santé de l’homme sont multiples et peuvent être à l’origine de certaines maladies inflammatoires des intestins plus ou moins graves (RCH, SII,…). On peut citer par exemple que la formation des gaz entraînant différents malaises qui vont du ballonnement aux mauvaises odeurs ou la libération de l’ammoniaque par la flore intestinale, après désamination des acides aminés et la production de certains composés phénoliques et indoliques, provenant de la dégradation de certains constituants alimentaires, suspectés d’être impliqués dans les mécanismes d’initiation du cancer du côlon. On peut citer également des problèmes de santé couramment rencontrés chez l’homme après ingestion de produits alimentaires contaminés par certains sérotypes enterohémorragique de la bactérie E. coli (EHEC) responsables d’infections variées allant de la diarrhée aqueuse à la colite hémorragique et pouvant évoluer vers d’autres maladies plus graves notamment des maladies rénales.
* Professeur à l'Université Ibn Zohr
Faculté des sciences d'Agadir, laboratoire
de biotechnologies microbiennes et protection
des végétaux (LBMPV)
Les premières formes microbiennes ont été alors observées par Antoni Van Leeuwenhoek en 1665 dans le tartre de ses dents, dans les matières fécales de l’homme et des animaux et dans le moût de bière. Il a pu convaincre la communauté scientifique de son époque de l’existence de ces particules vivantes invisibles à l’œil nu, mais actives dans leurs milieux. Des bactéries et des levures ont été alors observées et schématisées. Actuellement avec le rayonnement de la science microbiologique et de la technologie, l’homme est convaincu de l’existence de ce monde microbien aussi diversifié que complexe et qui cohabite avec lui sur la terre. De plus, non seulement il vit dans son environnement (eau, sol, air, débris végétaux,…), mais il tapisse également plusieurs parties de son corps (peau, muqueuses, intestins,…) et il est présent sur et dans tous les êtres vivants (végétaux, homme, animaux) sans exception.
Dans ce papier, on va s’intéresser plus particulièrement aux micro-organismes qui colonisent le tube digestif de l’homme et qu’on appelle plus communément « la flore microbienne intestinale ou microbiote intestinal». Le terme micro-organismes étant donné à tous les organismes cellulaires microscopiques (bactéries, levures, champignons microscopiques, protozoaires) à l’exception des virus qui sont considérés comme des particules non cellulaires mais actives, c'est-à-dire qu’ils peuvent infecter les cellules vivantes animales, végétales ou microbiennes et se multiplier dans ces cellules.
Groupes microbiens présents dans les intestins de l’homme en bonne santé : Flore microbienne intestinale
Parmi les premiers médecins qui ont travaillé sur la flore microbienne du tube digestif et sa relation avec la physiologie de la digestion, il y a un jeune pédiatre allemand, Theodore Escherich (1857-1911). Il a publié en 1886 une monographie sur les bactéries intestinales des nourrissons. Depuis ce temps, les études sur la flore intestinale de l’homme se sont multipliées pour déterminer les groupes microbiens qui la composent et leurs interactions avec le tube digestif. Elles ont montré que la flore intestinale de l’homme est constituée de plusieurs groupes de micro-organismes. En nombre, cette flore représente dix à cent fois plus de cellules que n’en contient le corps humain et peut atteindre 1014 unités ou cellules par gramme de matières fécales Elle se concentre, majoritairement, dans le gros intestin (côlon) où elle assure plusieurs interactions fonctionnelles et physiologiques.
La mise en culture du contenu intestinal (matières fécales) au début par des techniques bactériologiques classiques ou en anaérobiose (en absence d’oxygène), et plus tard par des techniques de biologies moléculaires développées, a permis de mettre en évidence plusieurs groupes de micro-organismes. Ces cultures ont mis en évidence une dominance bactérienne par rapport aux autres micro-organismes, ce qui a permis de les classer comme suit :
* Les micro-organismes anaérobies : ce groupe a pu être révélé grâce à l’évolution des techniques de culture en anaérobiose, c'est-à-dire en absence d’oxygène. Il est représenté par plusieurs genres. Les plus abondants sont cultivables dans les conditions de laboratoire et regroupent environ 400 espèces différentes, mais seule une quarantaine d’espèces constitue la flore dominante d’un individu. Ces espèces appartiennent aux genres Bacteroides, Eubacterium, Peptostreptococcus, Ruminococcus, Bifidobacterium, Fusobacterium.
* Les micro-organismes anaérobies facultatifs, c'est-à-dire ils peuvent êtres cultivés en absence ou en présence d’oxygène, sont moins représentés et composent la flore sous dominante (106 à 108 unités par gramme de matières fécales). Exemple de la bactérie la plus étudiée Escherichia coli.
* Les micro-organismes aérobies, c'est-à-dire ils ne peuvent se multiplier qu’en présence de l’oxygène, sont peu nombreux (106 unités par gramme de matières fécales) et souvent ils ne font que transiter dans le tube digestif.
D’une manière plus simple, on peut dire que l’ensemble de ces micro-organismes constitue ce qu’on appelle « la flore microbienne intestinale » et que cette flore dont le nombre est très élevé dans le côlon caractérisé par une motricité réduite et moins abondante dans l’intestin grêle, caractérisé par une motricité importante, est composée d’une:
• flore résidente, permanente et abondante capable de se multiplier dans le tube digestif et qui caractérise même un individu (c'est-à-dire chaque individu a sa propre flore intestinale). Cette flore est capable de se concerter avec certains organes de l’homme pour moduler l’expression de certains gènes des cellules intestinales afin de créer un environnement favorable à son implantation,
• flore de transit qu’on ne retrouve pas à chaque fois dans le tube digestif. Cette flore bactérienne provient de l’alimentation et appartient à différents genres bactériens. Par exemple, les probiotiques qui peuvent survivre dans le tube digestif sans le coloniser définitivement ou des espèces qui appartiennent à la famille des Enterobacteriaceae (Escherichia coli par exemple). et aux genres Streptococcus, Lactobacillus,…
Interactions entre la flore intestinale et le tube digestif
Aujourd’hui, il est bien connu que les micro-organismes qui constituent la flore intestinale interagissent ,d’une part, entre eux et ,d’autre part, avec les cellules du tube digestif de l’homme par le biais des mécanismes immunitaires et par les métabolites produits par les réactions de fermentation qui se produisent dans le tube digestif. Ces différentes interactions sont bénéfiques et parfois néfastes pour l’homme.
La flore intestinale n’a pas la même composition chez le nouveau-né, le nourrisson, l’enfant ou l’adulte. Elle varie en fonction des différentes parties du tube digestif, de l’alimentation, de l’hygiène de vie, de l’environnement et des traitements antibiotiques. Les espèces qui composent cette flore présentent un tropisme cellulaire et tissulaire spécifique et parviennent à s’implanter par endroit du tube digestif. Il existe aussi des relations d’interaction entre les différentes bactéries qui composent cette flore. Ces interactions jouent un rôle important dans la sélection, la possibilité de colonisation et la persistance de certaines souches pour faire partie de la flore résidente. A titre d’exemple, l’espèce bactérienne Escherichia coli est représentée par plusieurs souches dont quelques-unes parviennent à coloniser définitivement le milieu colique d’une personne et entrent en relation symbiotique avec elle, alors que d’autres sont de transit et sont particulièrement soit des formes potentiellement pathogènes qui peuvent entraîner plusieurs types d’infections soit des formes environnementales qui n’arrivent pas à s’implanter sur les tissus du côlon et qui se retrouvent éjectées avec les matières fécales en dehors de l’organisme.
Fonction de la flore microbienne intestinale
La flore microbienne intestinale est essentiellement bactérienne. Elle assure de nombreuses foncions bénéfiques. Notamment, des fonctions métaboliques (sources d’énergie, de certaines vitamines,…), des fonctions trophiques (développement du système immunitaire) et des fonctions de barrière (elle s’oppose à l’implantation des germes pathogènes). L’implantation de chaque groupe de micro-organismes au niveau du tube digestif (œsophage, estomac, intestin grêle, gros intestin) est fonction de ses paramètres physiologiques. En effet, dans l’estomac à pH acide, ces cellules microbiennes sont soient détruites soit elles transitent. Certaines cellules par contre trouvent le moyen de coloniser les parois de cette cavité, comme c’est le cas de la bactérie Helicobacter pylori responsable de l’ulcère de l’estomac.
Au niveau de l’intestin grêle, le pH est neutre et le niveau d’oxygène est faible. Dans ces conditions, plusieurs espèces microbiennes parviennent à séjourner pour quelque temps pour transiter ensuite vers le côlon. Au niveau des différents segments du côlon (ascendant, transverse, descendant et sigmoïde), l’implantation des micro-organismes est importante et elle est favorisée grâce au transit ralenti, à l’absence d’oxygène et à la présence du mucus (le mucus est un gel translucide de 50 à 450 μM d’épaisseur, adhérent à la muqueuse et filant,il est formé de polymères de mucoglycoprotéines sécrétés par des cellules épithéliales) et à la nature des substances nutritives disponibles (les glucides et les protéines non digérés dans la partie supérieure du tube digestif, ainsi que par les sécrétions endogènes). Toutes ces conditions favorisent l’installation d’une flore résidente essentiellement anaérobie, riche et variée et dont la composition change d’un segment à l’autre. D’un autre côté, il se produit un échange entre les différentes composantes de la flore microbienne et les cellules tissulaires du côlon, ce qui contribue à l’amélioration du système immunitaire de l’homme.
Causes du déséquilibre de la flore intestinale
Quel que soit l’âge d’une personne en bonne santé, un équilibre se crée entre les différents groupes de micro-organismes qui constituent sa flore intestinale. Chaque groupe cohabite avec l’autre en parfaite harmonie et se localise dans une partie du tube digestif en fonction des particularités physiologiques de chaque compartiment et constitue une sorte de barrière qui s’oppose à l’implantation des germes de transit. En cas de problèmes de santé liés à une mauvaise alimentation (alimentations non équilibrées, alimentations contaminées par des microbes ou des substances toxiques,…), à une antibiothérapie mal contrôlée ou autre, il se produit un déséquilibre de la flore intestinale, ce qui entraîne plusieurs maladies intestinales aiguës ou chroniques telles que les diarrhées, le syndrome de l’intestin irritable (SII), la maladie de Crohn (MC), rectocolite hémorragique (RCH) et les cancers coliques. Cependant, la flore intestinale peut être améliorée :
* en régulant certains facteurs abiotiques comme le pH, le mucus, la vitesse de transit,
* en ajoutant dans l’alimentation de nouveaux micro-organismes vivants en quantités adéquates et présentant la particularité d’influencer de manière bénéfique la fonction des intestins de l’homme. Les bactéries lactiques, la levure de bière et d’autres probiotiques sont utiles dans ce cas. Les probiotiques, selon la définition de l’OMS, sont des micro-organismes vivants qui, lorsqu’ils sont administrés en quantités adéquates, produisent un bénéfice pour la santé de l’individu.
* en éliminant les germes en cause avec une antibiothérapie contrôlée,
* en améliorant l’apport des facteurs nutritionnels aux micro-organismes de la flore intestinale résidente par l’apport de fibres alimentaires ou de prébiotiques. Les prébiotiques sont des ingrédients alimentaires non digestibles, comme les acides biliaires par exemple, qui stimulent de manière sélective, au niveau du côlon, la multiplication ou l’activité de certains groupes bactériens susceptibles d’améliorer la fonction intestinale tels que les bactéries lactiques appartenant au genre Bifidobacterium.
Les conséquences de ce déséquilibre sur la santé de l’homme sont multiples et peuvent être à l’origine de certaines maladies inflammatoires des intestins plus ou moins graves (RCH, SII,…). On peut citer par exemple que la formation des gaz entraînant différents malaises qui vont du ballonnement aux mauvaises odeurs ou la libération de l’ammoniaque par la flore intestinale, après désamination des acides aminés et la production de certains composés phénoliques et indoliques, provenant de la dégradation de certains constituants alimentaires, suspectés d’être impliqués dans les mécanismes d’initiation du cancer du côlon. On peut citer également des problèmes de santé couramment rencontrés chez l’homme après ingestion de produits alimentaires contaminés par certains sérotypes enterohémorragique de la bactérie E. coli (EHEC) responsables d’infections variées allant de la diarrhée aqueuse à la colite hémorragique et pouvant évoluer vers d’autres maladies plus graves notamment des maladies rénales.
* Professeur à l'Université Ibn Zohr
Faculté des sciences d'Agadir, laboratoire
de biotechnologies microbiennes et protection
des végétaux (LBMPV)